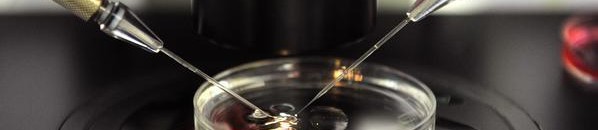
أداة ذكية لقياس خصوبة الرجال 10 1 760519

قد يتحول معرفة الخصوبة للإنجاب أمرا روتينيا يوميا يقوم به الرجال، وذلك من خلال تقنية جديدة تمكنهم من القيام بذلك في أي مكان باستخدام الآيباد.
وتأمل شركة “آيدميكس” بالاستفادة من سوق الخصوبة البشرية العالمية التي تبلغ قيمتها 40 مليار دولار، بأداة ذكية تتوافق مع الآيباد أطلقت عليها اسم (آي سبيرم).
ولا تعد هذه الأداة الأولى في مجال فحص الحيوانات المنوية منزليا، لكنها الوحيدة التي توفر معلومات فورية عن نسبة الخصوبة مع صور حية للحيوانات المنوية.
وتستند التقنية الجديدة على مبدأ بسيط، إذ يقوم مجهر صغير بتكبير نقاط قليلة من السائل المنوي توضع داخل أنبوب صغير تركز عليه الإضاءة من الخلف، لتنعكس صورة الحيوانات المنوية المتحركة على كاميرا جهاز آيباد، وحينها سيعمل برنامج الأداة على تحليل العينة وإحصاء العدد الإجمالي للحيوانات المنوية وحساب سرعة حركتها.
يذكر أن هذا المنتج كان قد ابتكر في بادئ الأمر لمساعدة أصحاب قطعان الماشية، لكن مؤسسها أجين لين يعتزم اليوم الحصول على موافقة إدارة الأغذية والأدوية الأميركية “إف دي إيه” في العام المقبل لتوسيع استخدامها للرجال.
سكاي نيوز